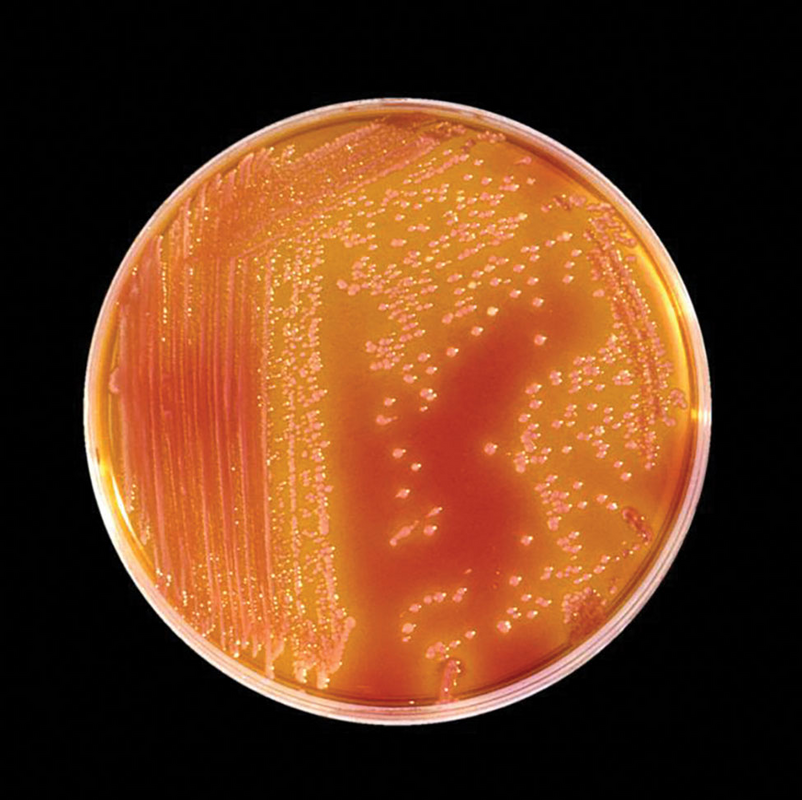

Serratia marcescens, которая может вызывать нозокомиальные вспышки, инфекции мочевыводящих путей и ран, в изобилии встречается во влажной среде.
Грамотрицательная бактерия семейства Yersiniaceae, факультативный анаэроб. Ее можно легко обнаружить в ванных комнатах, включая душевые кабины и раковины, где она имеет розово-оранжево-красную окраску, обусловленную пигментом, известным как продигиозин. Serratia была обнаружена в Италии в 1819 году в кукурузной муке в небольшом городке недалеко от Падуи.
Бартоломео Бизио, венецианский фармацевт, изучил бактерий и назвал их Serratia в честь Серафино Серрати, который провел первый пароход по реке Арно в 1795 году, предвосхитив открытие Роберта Фултона в 1807 году. Слово marcescens было выбрано для латинского названия вида и означает "разлагаться", что отражает быстрое разрушение пигмента. Serratia marcescens позже была переименована в Monas prodigiosus в 1846 году, затем в Bacillus prodigiosus, после чего первоначальное название было восстановлено в 1920-х годах в знак признания работы Бизио.
Культура Serratia marcescens. Колонии имеют красный цвет из-за пигмента (продигиозина), вырабатываемого этим организмом. Источник: Centers for Disease Control and Prevention, 1985.

"Кровавый хлеб": S. marcescens растет на хлебе.
